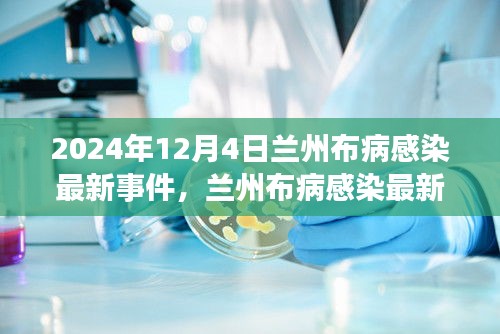

尊敬的读者朋友们,近期关于兰州布病感染事件引起了社会各界的广泛关注,本文将围绕这一事件展开深入讨论,重点关注最新的感染情况、防控措施以及公众关心的热点问题,本文旨在传递权威信息,普及防控知识,共同应对这一挑战。
事件背景概述
让我们回顾一下事件的背景,布病,即布鲁氏菌病,是一种由布鲁氏菌引起的人畜共患传染病,兰州作为西北地区的重要城市,近年来畜牧业发达,布病感染事件时有发生,本次事件发生在2024年12月4日,引起了社会各界的广泛关注,目前,兰州市政府已经采取了一系列措施应对此次事件。
最新感染情况分析(要点一)
截至目前为止,经过相关部门紧密排查和检测,本次布病感染事件已确诊多例病例,感染源主要集中在一个特定的地区,与当地的畜牧业活动密切相关,目前,感染者主要集中在特定年龄段和特定职业群体,但仍有散发病例出现,防控形势依然严峻。
防控措施分析(要点二)
针对此次布病感染事件,兰州市政府已经采取了一系列防控措施,加强了对畜牧业的监管力度,对养殖场进行全面排查和消毒,加强了对人员的培训和管理,提高群众对布病的认识,加强个人防护意识,还加大了对医疗资源的投入,提高医疗救治能力,这些措施的实施将有助于遏制疫情扩散。
科普知识普及(要点三)
为了更好地应对布病感染事件,普及防控知识至关重要,布病主要通过接触感染布鲁氏菌的动物或其产品传播给人,公众应尽量避免接触未经检疫的肉类、奶制品等食品,保持良好的个人卫生习惯,如勤洗手、戴口罩等也是预防布病的关键,对于从事畜牧业的人群来说,更应严格遵守相关防护措施,确保自身安全。
公众热点问题解答
针对公众关心的热点问题,相关部门已经进行了回应和解答,关于疫苗的问题,目前针对布病的疫苗已经研制成功并在部分地区推广使用,关于疫情扩散的问题,政府已经采取了多项措施进行防控,确保疫情不会大规模扩散,关于治疗问题,目前布病是可以治愈的,患者只需积极配合医生治疗即可。
本次兰州布病感染事件引起了社会各界的广泛关注,面对这一挑战,我们应保持冷静、理性应对,通过加强防控措施、普及防控知识、回应公众热点问题等方式,共同应对布病感染事件,我们相信,在政府和公众的共同努力下,一定能够战胜这一挑战,保障人民群众的生命安全和身体健康。
希望本文能为大家提供有价值的信息和建议,共同应对布病感染事件,让我们携手共进,共同为疫情防控贡献力量!
转载请注明来自河南双峰网袋厂,本文标题:《探寻真相与防控措施,兰州布病感染最新事件报道》

豫ICP备19030322号-1
豫ICP备19030322号-1
还没有评论,来说两句吧...